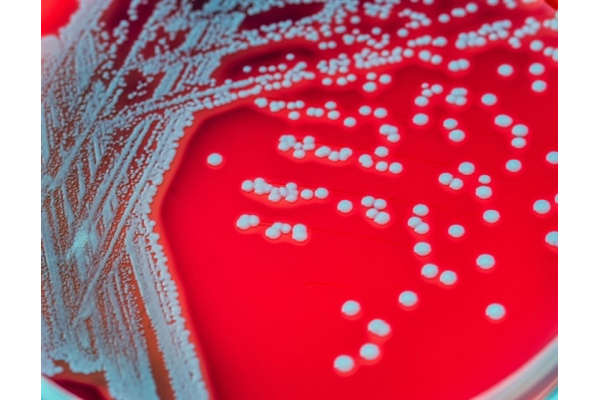

2023-04-24
来源: drugdu
322
cedars-sinai研究人员发现了一种基因变异,它会增加人们患肛周克罗恩病的风险,这是克罗恩病最令人衰弱的表现。
该变体会产生dna变化,导致蛋白质功能丧失,进而改变身体识别和处理细菌的方式,使其对抗感染的效果降低。
这一发现发表在同行评审期刊《gut》上。
该研究的共同高级作者、cedars-sinai f.widjaja基金会炎症性肠病和免疫生物学研究所转化研究主任dermot mcgovern医学博士、joshua l.和炎症性肠疾病遗传学主席lisa z.greer表示:“瘘管病可能是一种非常痛苦的情况。我们目前的治疗方法确实不太擅长治疗,因此这项研究解决了一个非常重要的未满足医疗需求的领域。通过了解潜在原因,我们可以开始为诊断为这种慢性炎症疾病的患者制定新的治疗策略,其中大多数患者目前需要手术,通常需要多次手术。”
肛门周围克罗恩病是克罗恩病的一种并发症,克罗恩病为一种影响消化道的慢性炎症性疾病。该并发症会导致肛门周围皮肤以及肛门周围其他结构的炎症和溃疡。高达40%的克罗恩病患者患有肛周克罗恩病,治疗反应有限,导致生活质量低下。
作为该研究的共同第一作者兼麦戈文实验室研究助理教授,talin haritunians博士表示:“我们在识别与疾病发展风险相关的基因变异方面取得了更大的成功,但我们在这里所做的是专门关注克罗恩病的一种非常复杂和严重的表现。这是基因研究中一种不同寻常的方法。”
为了发现与这种严重表现直接相关的基因变异,研究人员分析了三个独立的克罗恩病患者队列的基因数据。这些小组包括一个cedars-sinai队列,一个从20多个国家招募的国际遗传学队列,以及一个从美国七个学术研究医疗中心招募的队列。这三组共有4000名肛周克罗恩病患者和11000多名没有这种并发症的克罗恩病病人。
科学家团队比较了这些队列,看看他们是否能检测到基因座,这些基因座是与这种表现相关的基因组区域。同时,他们确定了10个新的遗传基因座和14个已知的炎症性肠病基因座与肛周并发症的发展有关。
在功能表征分析过程中,该团队将重点放在一种名为snp的特定基因的单一变化上,该基因与肛周克罗恩病有关。这种基因变异会影响一种名为补体因子b(cfb)的蛋白质,导致这种对对抗感染很重要的蛋白质失去功能,这可能就是为什么这种基因变化的患者更有可能患上这种疾病的原因。
研究人员进行了多次分析,以证实cfb确实存在功能丧失,这可能会对身体产生巨大影响。
该研究的共同高级作者、雪松西奈大学医学和生物医学科学研究助理教授kathrin michelsen博士说:“在这种突变导致无功能蛋白质的情况下,你不会得到正常的信号级联,身体也不会意识到细菌是有害的,因此这些细菌不会被消灭。因此,对于那些患有肛周克罗恩病的患者来说,从直肠到皮肤区域都有连接。这些隧道里充满了没有被消除的细菌。”
michelsen还指出,这项研究证明了替代补体途径和cfb在肛周克罗恩病发展中的重要作用。研究结果还表明,靶向替代补体途径可能是治疗克罗恩病这种致残表现的一种新的治疗方法。
这种基因变异也可能与其他疾病有关。
麦戈文说:“这些基因变异往往会导致多种疾病,我们相信这一发现也可能对其他疾病产生影响,而不仅仅是克罗恩病。”。
研究人员目前正致力于确定与肛周克罗恩病和炎症性肠病中其他未满足医疗需求的领域相关的额外基因变异的功能。
marzieh akhlaghpour博士曾是cedars-sinai的研究生,是这项研究的共同第一作者。cedars-sinai的其他作者包括shyam k.more、lisa s.thomas、dalton t.stamps、shishir dube、dalin li、shaohong yang、carol j.landers、emebet mengesha、hussein hamade、ramachandran murali、alka a.potdar、andrea j.wolf、gregory j.botwin、michelle khrom、gil y.melmed、eric a.vasiliauskas、christina ha、gaurav syal、nirupama n.bonthala和stephan targan。
文章转载于:
责编: editor您已成功订阅,无需重复提交。
确认
请输入正确邮箱!
订阅
邮件订阅热门医贸资讯,了解第一手信息。